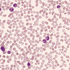

A 63-year-old male was hospitalized following a massive hemorrhage secondary to a motor vehicle accident and subsequent infection of a surgical site. Three weeks post-admittance his white blood cells (WBC) demonstrated a marked elevation (40,000/mm3). Subsequent laboratory tests showed a very high leukocyte alkaline phosphatase score, whereas the PCR for the BCR-ABL fusion gene was negative. Click here to see the whole slide image.
Click here for the comparative pathology.
What is your most likely diagnosis?